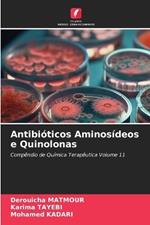

IBS.it, l'altro eCommerce
L’articolo è stato aggiunto alla lista dei desideri
Libri di Derouicha Matmour
Reparti
Offerte
Prezzo (€)
Autori
Vedi tutti
Mostra meno
Editori e marche
Vedi tutti
Mostra meno
Formato
Venditore
Tutti i risultati (39)
Informazioni sull’ordinamento
Vengono mostrati per primi i prodotti che rispondono a questi criteri: rilevanza rispetto alla ricerca, dati di venduto, disponibilità, data di pubblicazione, tipologia di prodotto, personalizzazione ad eccezione delle sponsorizzazioni.